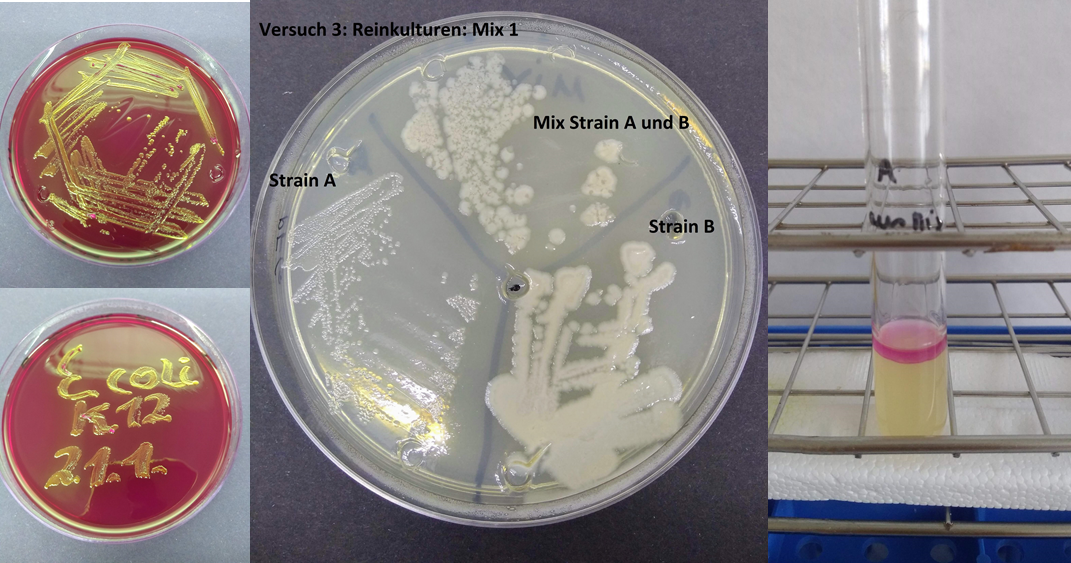
Fascinating_world_of_microbes_II

.
Teaching

Master course in corona-times

Get-together for data assessment
.

Molecular biology ready for action
.
Fascinating world of microbes
.

Course in Namibia at NUST as part of the TOPSOIL project
.
Prof. Barbara Reinhold-Hurek
Head of the BMB Admission and Examination Board
Organizer and contact person for specialization Microbial Systems (MicroSys) in the BMB Master's program
Bachelor
BSc Biologie
| VL Grundvorlesung Mikrobiologie 02-02-MBW2-1 (WS) |
| P Grundkurs Mikrobiologie 02-02-MBW2-2 (WS) |
| VL Methoden der Molekularen Biowissenschaften 02-2-PM1.7 (WS) |
| Ü + S + P Gentechnisch-Mikrobiologisches Praktikum 02-02-PM3MOL1 (WS) |
| VL Aktuelle Forschungsthemen der Molekularen Biowissenschaften 02-02-PM2Mol2 (WS) |
| VL + Ü Präsentation wissenschaftlicher Daten mit Beispielen aus der Mikrobiologie PM1.17 (WS) |
| VL Methoden der Mikrobiellen Ökologie PM1.18 (WS) |
| VL Faszination Biowissenschaften 02-02-GS3 (WS) |
Master
MSc in Biochemistry and Molecular Biology (BMB)
| VL + S Basics in Biochemistry and Molecular Cell Biology 02-317-7-400a (WS) |
| P Methods in Biochemistry and Molecular Cell Biology 02-317-7-400 b (WS) |
| VL + S Methods for Biomolecular Research 02-317-7-pilot1 (WS) |
| VL + S Organismic Models for Bioscience Research 02-317-7-pilot2 (WS) |
| S Models, Methods, Specialization: Specialization MicroSys and Company Contacts (WS) |
| Workshop Biochemistry and Molecular Biology 02-317-7-403c (WS) |
| VL + S Project Management (Communication, MicroSys and Patenting) (SS) |
| VL + P Bacterial Genomes: Bioinformatics, mutant construction and proteomics 02-317-8-434 (SS) |
| VL + P Functional Genomics of bacteria: RNA and microarray analysis 02-317-8-436 (SS) |
| VL Molecular Medicine 02-8-317-441 (SS) |
| Project Proposal and defense 02-317-8-422 (SS) |
